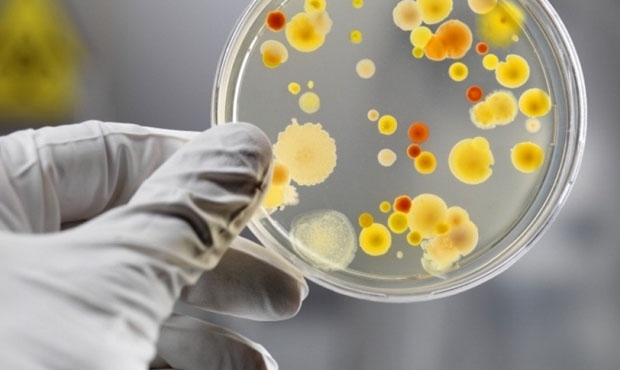

Жителя Красноярского края положили в Вихоревскую горбольницу с подозрением на COVID-19
Утром 22 апреля в инфекционное отделение Вихоревской городской больницы поступил житель Красноярского края с ОРВИ – у него подозревают коронавирусную инфекцию. Об этом сообщает пресс-служба Братской районной больницы.
Больному 28 лет, медики оценивают его состояние как средней степени тяжести. В настоящее время в инфекционном отделении медучреждения находятся четыре человека – у двоих коронавирус не обнаружен.
На сегодняшний день в Иркутской области зарегистрировали всего 79 случаев заражения COVID-19. 13 человек полностью излечились, трое умерли.
_(1)_15165630_b.jpg)




















